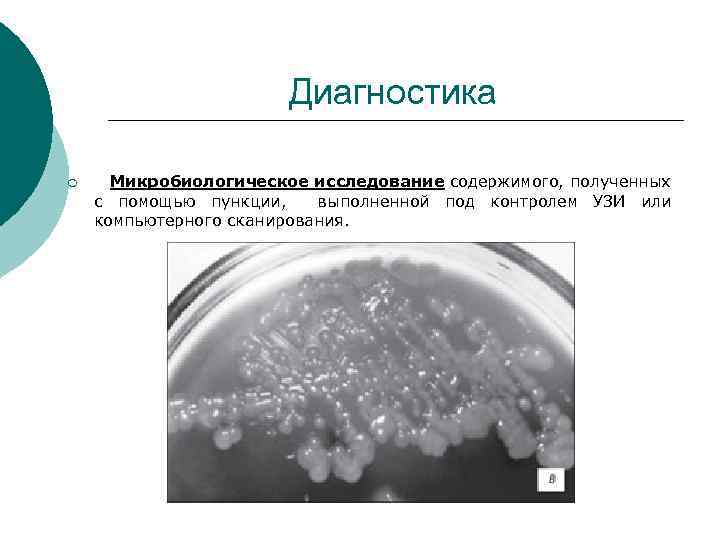
Диагностика ¡ Микробиологическое исследование содержимого, полученных с помощью пункции, выполненной под контролем УЗИ или

Абсцессы ПЖ.ppt
- Количество слайдов: 19

КАЗАНСКИЙ ГОСУДАРСТВЕННЫЙ МЕДИЦИНСКИЙ УНИВЕРСИТЕТ КАФЕДРА ХИРУРГИЧЕСКИХ БОЛЕЗНЕЙ № 2 Абсцессы поджелудочной железы ПОДГОТОВИЛ: интерн АБШИЛАВА И. И.

¡ Абсцессы поджелудочной железы это осложнение острого деструктивного панкреатита, представляеющиеся собой ограниченные внутрибрюшные скопления гноя, обычно локализующиеся внутри поджелудочной железы или рядом с ней.

¡ К абсцессам поджелудочной железы относятся также нагноившиеся ложные кисты. Абсцессы поджелудочной железы являются поздними осложнениями острого панкреатита, возникающими не ранее 4 -й недели от начала заболевания; они нередко сопровождаются общими симптомами гнойного заболевания.

Классификация абсцессов поджелудочной железы: 1. Внутрипанкреатические множественные); абсцессы (единичные и 2. Единичные абсцессы парапанкреатической клетчатки (в области головки, тела и хвоста); 3. Множественные клетчатки абсцессы парапанкреатической

¡ Также абсцессы могут быть: - однополостными; - многополостными.

Этиология ¡ Абсцессы поджелудочной железы могут быть вызваны каким-либо одним микроорганизмом или смешанной микрофлорой. Чаще всего высевается один возбудитель. В 51 % случаев это бывает Escherichia соli. Кроме того, обнаруживаются Enterococcus, Staphylococcus aureus, Pseudomonas, Proteus mirabilis, Klebsiela, Streptococcus faecalis и различные штаммы Bacteroides. Считается, что микроорганизмы, проходя через кишечную стенку (так называемый процесс транслокации бактерий), проникают в поджелудочную железу с лимфой.
Диагностика ¡ Микробиологическое исследование содержимого, полученных с помощью пункции, выполненной под контролем УЗИ или компьютерного сканирования.

¡ Рентгенологическое исследование включалет в себя рентгенографию грудной клетки, желудка, фистулографию. При рентгенологическом исследовании желудка оцениваются рельеф слизистой оболочки, признаки сдавления извне, скорость прохождения бариевой кашицы по желудку и двенадцатиперстной кишке. Признаки оттеснения желудка абсцессом поджелудочной железы. фистулография выполняется в среднем на 5 сутки после дренирования. Применение этого метода позволиляет оценить форму, объем, размеры, контуры образования, выявить сообщение с полыми органами и контролировать изменение размеров в динамике.

¡ Эндоскопическое исследование. При ФЭГДС чаще всего отмечалются признаки оттеснения желудка и 12 п. к. увеличенной головкой поджелудочной железы с признаками нарушения эвакуации.

¡ ¡ Ультразвуковое сканирование брюшной полости На основании данных ультразвукового исследования вычисляется объем образования, оценивалют изменения поджелудочной железы, определяют наличие секвестров. Чувствительность УЗИ в диагностике составляет 99%, специфичность – 55, 5%. К достоинствам этого метода исследования следует также отнести его доступность, неинвазивность и отсутствие противопоказаний. Однако относительно низкая специфичность приводит к значительным трудностям в дифференциальной диагностике острых жидкостных скоплений, острых кистойдов и острых абсцессов поджелудочной железы (согласно позициям Атлантской классификации острого панкреатита, 1992 г).

Инфильтрат в проекции большого сальника с анэхогенным включением до 4 см (абсцедирование).


¡ Компьютерная томография. Абсцессы поджелудочной железы на компьютерных томограммах предстают в виде нечетких скоплений жидкости смешанной плотности. К сожалению, таким же образом проявляются и ненагноившиеся ложные кисты поджелудочной железы, и флегмона забрюшинного пространства. Газ в полости кисты свидетельствует о наличии газообразующих микроорганизмов.

Лечение ¡ Малоинвазивная методика, включающая пункции, дренирование жидкостных образований под контролем ультразвука или КТ и санационную эндоскопическую чресфистульную оментобурсоскопию (СЭЧОБС).

1. Малоинвазивные манипуляции под контролем ультразвука или КТ включалют в себя чрескожную пункцию и дренирование абсцесса поджелудочной железы. Пункции и дренирование проводятся под постоянным визуальным УЗ- или КТконтролем за продвижением иглы или стилеткатетера. Траекторию выбиралют с помощью фиксирующего устройства пункционного датчика, основываясь на полученном векторе кратчайшего расстояния от передней брюшной стенки до абсцесса, минуя полые органы и сосуды. После такого дренирования рекомендуют выполнять ЯМР – томографию для выявления остаточных некрозов и выпота.

Панкреатические абсцессы с несколькими полостями или содержащие значительное количество твердых некротических масс не подлежат чрескожному дренированию и должны быть вскрыты, санированы и дренированы хирургическим методом. Однако при высоком риске хирургического вмешательства чрескожная пункция и дренирование могут стать предварительной операцией, позволяющие снизить интоксикацию, проявления сепсиса и полиорганной недостаточности.

2. Санационная эндоскопическая чресфистульная оменто-бурсоскопия применяется в стадии гнойных осложнений панкреонекроза с формированием ограниченных абсцессов поджелудочной железы и сальниковой сумки, содержащих секвестральные массы. В качестве подготовительного этапа для проведения санационной чресфистульной эндоскопической оментобурсоскопии производится бужирование дренажного канала, которое выполняется с помощью набора полых бужей из нержавеющей стали диаметром от 5 мм до 15 мм. Во время манипуляции (СЭЧОБС) производится оценка формы и размеров гнойника, визуализируется карманы и затеки, выполняется эвакуация гноя и фрагментов секвестра путем промывания полости растворами антисептиков, что позволялет санировать гнойные полости малоинвазивным методом.

¡ Традиционное оперативное лечение в объеме наружного дренирования сальниковой сумки или оментобурсостомии.

Спасибо за внимание!
Абсцессы ПЖ.ppt